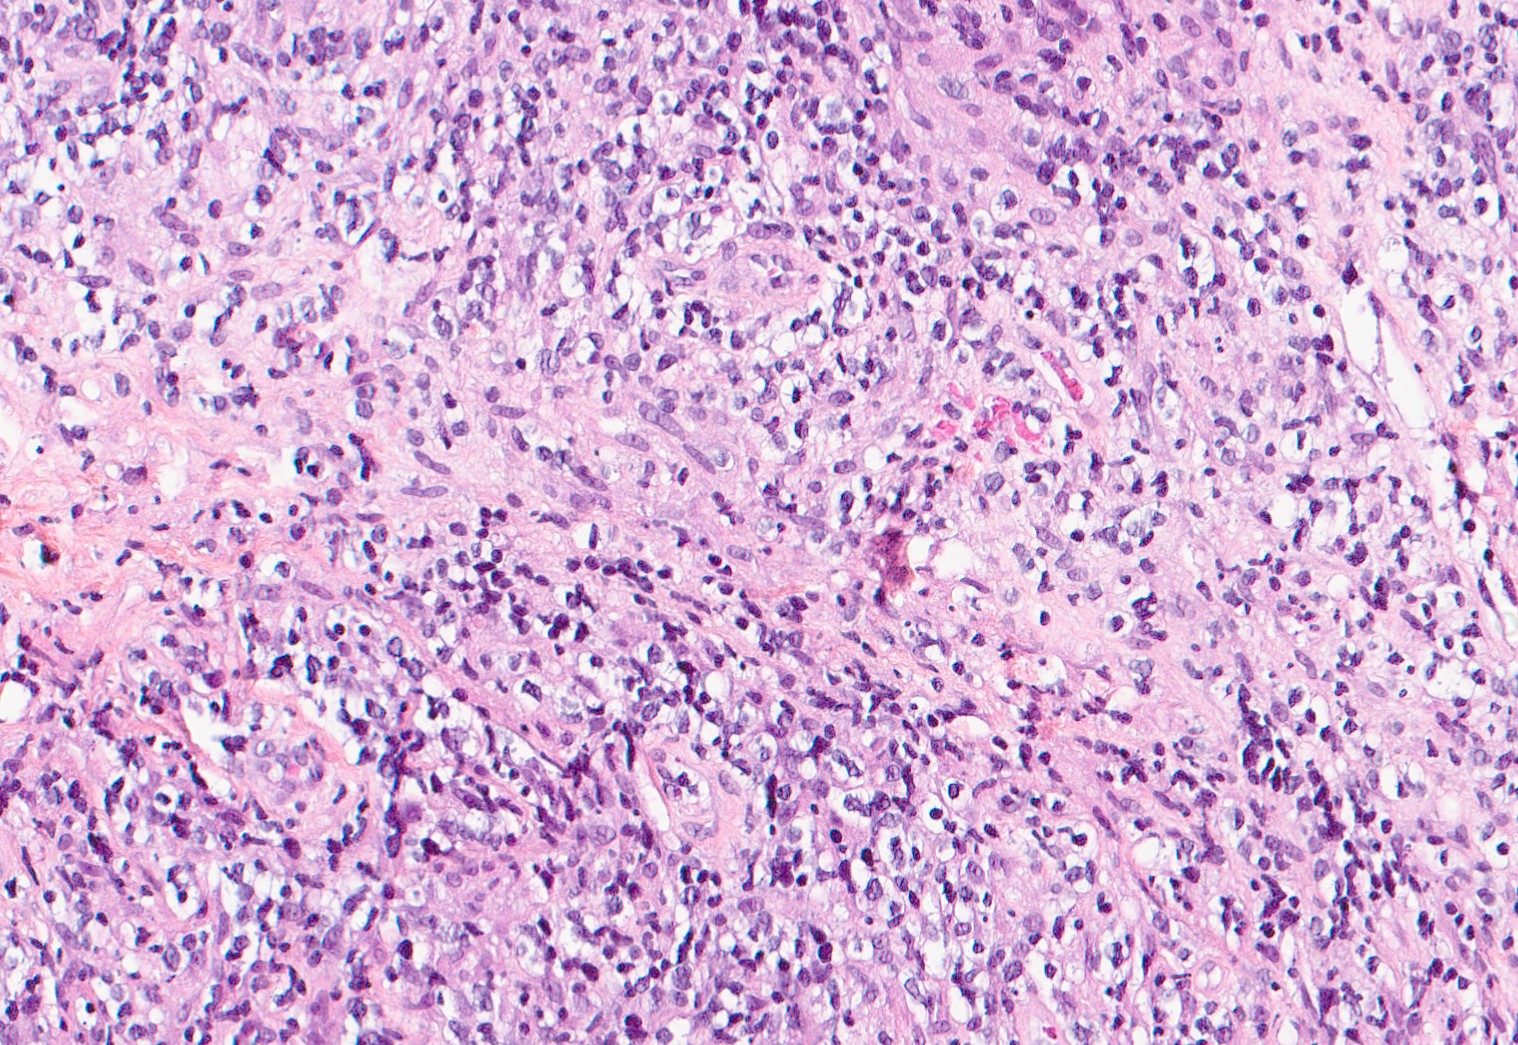

De la lame à l'écran : La coloration virtuelle en pratique
Exploration des mécanismes sous-jacents de la coloration virtuelle

Grâce à une architecture fondée sur le deep learning, les algorithmes de coloration virtuelle sont entraînés sur des milliers de paires d’images tissulaires. Ainsi, en analysant simplement les scans de lames de pathologie non colorées, le logiciel de coloration virtuelle génère à l’écran des lames H&E et IHC prédites.
En reliant la recherche de pointe à la réalité du terrain, nous aidons les laboratoires à gagner du temps, réduire l'utilisation de réagents chimiques et créer de la valeur pour le patient.

Coloration sans marquage
La toute première catégorie de coloration virtuelle est dite « sans marquage » (label-free staining). Elle transforme des images d’autofluorescence de coupes non colorées en colorations H&E.

Conversion de coloration à coloration
Comme son nom l’indique, la deuxième catégorie de coloration virtuelle convertit un type de coloration en un autre. La conversion la plus courante est celle des lames H&E vers les colorations immunohistochimiques (IHC)

Marquage Multiplex In Silico
Cette troisième classe de coloration virtuelle prédit l'expression de multiples biomarqueurs protéiques directement à partir d'images H&E. Elle permet le phénotypage cellulaire computationnel et l'analyse du microenvironnement tumoral.
L'IA en pathologie et Virtual Staining : exemples d'études de validations scientifiques
Découvrez notre résumé d'articles scientifiques
Précision validée (SSIM)
Sur un jeu de données de 523 échantillons, Zhang et al. ont démontré que la coloration sans marquage (label-free) peut générer de manière fiable des prédictions de coloration H&E de haute qualité, présentant une forte similitude structurelle avec les colorations physiques.
Revue par des pathologistes
Dans le cadre d'une étude en double aveugle, des pathologistes ont comparé des lames réelles et des lames colorées virtuellement (250 échantillons). L'étude confirme que les colorations générées par l'IA permettent des diagnostics concordants, avec une qualité structurelle et perceptuelle élevée (De Haan et al., 2021).
Réferences
De Haan, K. et al. Deep learning-based transformation of H&E stained tissues into special stains. Nat Commun 12, 4884 (2021).
Zhang, Y. et al. Digital synthesis of histological stains using micro-structured and multiplexed virtual staining of label-free tissue. Light Sci Appl 9, 78 (2020).
Rendu de haute qualité et précision
À partir d'échantillons biopsiques de cancer du sein, Klöckner et al. (2025) ont validé un pipeline d'apprentissage profond (deep learning) capable de traduire le H&E en marquages IHC virtuels (RE, RP, HER2, Ki-67).
Sur de multiples cohortes de test, le modèle a démontré une forte similitude structurelle et perceptuelle avec l'immunohistochimie réelle, l'algorithme PSPStain obtenant les meilleures performances.
Références
Klöckner, P. et al. H&E to IHC virtual staining methods in breast cancer: an overview and benchmarking. npj Digit. Med. 8, 384 (2025).
Pertinence clinique validée multi-sites
Sur 4 jeux de données indépendants, l'algorithme a démontré une prédiction robuste de 50 biomarqueurs protéiques à partir de simples lames H&E.
Performance : L'algorithme surpasse significativement les modèles de référence basés uniquement sur le H&E et la morphologie.
Phénotypage : L'analyse a permis une classification précise de 7 types cellulaires, avec une performance comparable à la vérité terrain (ground-truth).
Références
Wu, E. et al. ROSIE : AI generation of multiplex immunofluorescence staining from histopathology images. Preprint at https://doi.org/10.1101/2024.11.10.622859 (2024).
Détection de précision des biomarqueurs sur toute lame...
Quel est l'intérêt clinique ?
La détection précise des biomarqueurs constitue le fondement de la médecine de précision. En identifiant les signaux moléculaires pertinents, le pathologiste peut orienter vers une oncologie plus personnalisée et ciblée.
Chez RainPath, notre suite logicielle propulsée par l'IA est conçue pour assister votre laboratoire, renforcer la confiance diagnostique et vous préparer à l'ère de la médecine de précision.
Découvrez notre cas d'usage sur l'identification de biomarqueurs : Ki-67
Pourquoi la tendance actuelle de l'IA et de la pathologie numérique est-elle fiable ?
Découvrez notre revue d'actualité sur les cas d'usage de l'IA en santé numérique.
Les modèles d'IA pour la coloration virtuelle reposent sur de vastes jeux de données d'entraînement, comprenant des centaines, voire des milliers d'images de lames de biopsie appariées (paired biopsy slide images).
Validation rigoureuse : Comme illustré précédemment, ces modèles sont validés sur des cohortes de données internes et externes.
Certification par les pairs : La validation est assurée par des pathologistes certifiés sur de multiples sites anatomiques, incluant les glandes salivaires, la thyroïde, le rein, le foie et le poumon (Rivenson et al., 2019).
OSAIRIS:
Addenbrooke’s Hospital, UK
Le Dr Raj Jena et son équipe ont utilisé l'IA pour la segmentation automatique des organes.
Impact : Réduction du temps de planification de la radiothérapie d'un facteur 2,5 (passant de plusieurs heures à quelques minutes).
iSeg:
Northwestern University, USA
Les Drs Abazeed et Teo ont déployé un modèle de deep learning 3D pour segmenter les tumeurs pulmonaires sur des poumons en mouvement lors de la planification radique.
Impact : Amélioration significative de la précision de la détection tumorale.
Sarkar, S., Teo, P. T. & Abazeed, M. E. Deep learning for automated, motion-resolved tumor segmentation in radiotherapy. npj Precis. Onc. 9, 173 (2025).
NHS, UK:
Le NHS a déployé un outil d'IA analysant les scanners cérébraux au sein de 107 centres spécialisés dans les AVC (Unités Neuro-Vasculaires) en Angleterre.
Résultat clinique : Augmentation du taux de récupération complète des patients de 16 % à 48 %.
NewYork–Presbyterian Hospital, USA:
Le Dr Poterucha et son équipe ont développé un modèle d'apprentissage profond (EchoNext) entraîné sur plus d'un million de dossiers combinant ECG et imagerie.
Performance : Des études de validation externe contrôlées ont démontré qu'EchoNext identifie les cardiopathies structurelles (structural heart disease) avec une précision supérieure à celle des cardiologues.
Poterucha, T. J. et al. Detecting structural heart disease from electrocardiograms using AI. Nature 644, 221–230 (2025).
.svg.png)